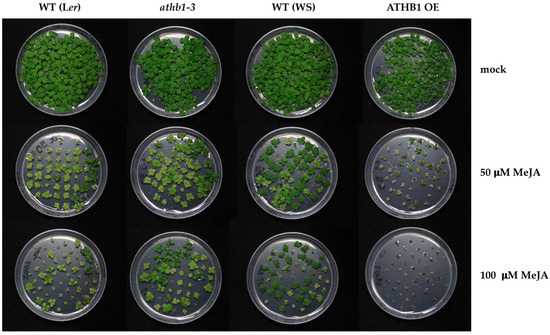

Abstract
ATHB1, an Arabidopsis thaliana homeodomain-leucine zipper (HD-Zip) transcription factor, is involved in the control of leaf development and hypocotyl elongation under short-day conditions. As growth adaptation to environmental conditions is essential for plant resilience, we investigated the role of ATHB1 in the interaction between transcriptional regulatory networks and hormone signaling pathways. We found that wounding, flooding and ethylene induce ATHB1 expression. In addition, we found that the ethylene signal transduction pathway is also involved in an age-dependent ATHB1 expression increase in leaves. Conversely, methyl jasmonate (MeJA) application decreases the ATHB1 transcript level. By exploiting mutant and over-expressing (OE) lines, we also found that the ATHB1 level influences plant sensitivity to the inhibitory effect of MeJA treatment on growth. To gain deeper insights into the regulatory pathways affected by ATHB1, we performed a microarray analysis comparing the transcriptome of wild-type and athb1 mutant plants following exposure to MeJA. Remarkably, although the response to the MeJA treatment was not impaired in athb1, several genes involved in jasmonate and salycilic acid signaling were already downregulated in athb1 seedlings under normal conditions compared to the wild type. Thus, our study suggests that ATHB1 may integrate different hormone signaling pathways to influence plant growth under various stress conditions.
1. Introduction
Plants have evolved intricate adaptive mechanisms to survive biotic and abiotic stresses, activating defense responses through hormone signaling and transcriptional networks. Despite these responses, stress conditions frequently diminish crop yields, presenting economic challenges. With most of the cultivated land worldwide experiencing a single or a combination of stresses, exacerbated by climate change, there is a critical need for resilient crop varieties capable of maintaining high productivity while conserving natural resources. This necessitates extensive research to improve our understanding of plant stress responses and advance genetic technologies for developing resilient varieties. Plant stress tolerance relies on molecular and biochemical adjustments, enabling cells to repair stress-induced damage, accumulate protective molecules, and restore cellular balance. Additionally, triggering developmental changes, such as lateral root and root hair growth during drought, can enhance resource utilization and mitigate stress impacts on the plant. The stress-induced changes in plants can occur in various cellular compartments and are regulated across multiple levels, including perception, signal transduction, transcriptional, post-transcriptional, translational, and post-translational regulation [1].
Hormones play a crucial role in signal transduction and integrating developmental and environmental cues, with some responses being common across different stresses, while others are stimulus-specific [2,3]. Abscisic acid (ABA) is the key regulator in abiotic stress conditions like drought, high salinity, and extreme temperatures. On the other hand, ethylene, jasmonic acid (JA) and salicylic acid (SA) are primarily induced by pathogen attack and wounding, and they are mainly involved in biotic stress responses. Extensive research has demonstrated intricate interactions among these hormones, with both synergistic and antagonistic effects. For example, ethylene interacts with JA and ABA signaling in a cooperative manner in plant defense against pathogen attack [2] and antagonistically in stomatal closure [4]. These interactions occur at various levels within hormone signaling pathways, forming complex regulatory networks that integrate external and internal signals for plant protection and acclimation to the environment. This integration involves genetic reprogramming and modulation of the expression of numerous stress-inducible genes by transcription factors (TFs) [5,6]. Several classes of TFs, including AP2/ERF, DREB, HD-ZIP, NAC and WRKY, are particularly responsive to external stimuli and some TFs have been shown to play an important role in biotic and abiotic stress responses.
Transcriptional changes in response to treatments with ABA have been observed for several Arabidopsis HD-Zip I genes [7], and there is evidence that members of clades I and II of the HD-Zip I family have roles related to drought stress and ABA signaling in different plant species [8,9,10,11]. In agreement, phenotypic and transcriptomic analysis of transgenic plants have shown that, in most of the assessed cases, over-expression of HD-Zip I proteins improves drought tolerance, likely through the activation/repression of a set of common target genes [12]. Nonetheless, in addition to the positive effects on water stresses, the over-expression of HD-Zip I proteins very often resulted also in undesirable alterations of the shape and growth of the plant, limiting their potential application for crop improvement and suggesting a role for HD-Zip I proteins in specific growth and/or developmental pathways [12,13]. This role has been clearly shown for ATHB1, the founder member of the HD-Zip I family [14]. ATHB1 has been shown to affect cotyledon expansion and leaf palisade cells development when over-expressed in tobacco [15], and to affect leaf development and margin serration in Arabidopsis by directly repressing miR164, a negative regulator of CUC2 [16]. Moreover, it has been demonstrated that ATHB1 plays a role in hypocotyl growth under a short-day regime [17]. Furthermore, ATHB1 expression has been found to be suppressed by drought, ABA, and NaCl in plants cultured in vitro [7], yet conversely induced following severe drought treatment in soil-grown plants at the reproductive stage [12]. In this condition, the ATHB1 OE plants were found to be drought-tolerant compared with their controls, whereas the athb1-1 mutant plants were more sensitive [12]. Finally, it has been reported that ATHB1 expression is positively regulated by ethylene in Arabidopsis [18], whereas the tomato ortholog HB1 directly regulates the expression of 1-AMINOCYCLOPROPANE-1-CARBOXYLATE OXIDASE (ACO) gene encoding a key enzyme in ethylene biosynthesis [19]. Although these studies demonstrate an effect of environmental conditions on ATHB1, its interaction with the transcriptional regulatory and hormonal networks that connect plant development and stress responses remains largely unknown.
To further investigate ATHB1′s function, we analyzed ATHB1 expression and found that it is induced by flooding, wounding and ethylene. Moreover, the ethylene signaling pathway was shown to contribute to the developmentally regulated increase of ATHB1 expression observed in leaves during aging. Additionally, we found that MeJA treatment represses ATHB1 expression while ATHB1 activity increases MeJA sensitivity. In fact, ATHB1 OE and athb1 mutant plants display an opposite behavior with increased and reduced growth impairment upon MeJA application, respectively. Nonetheless, comparative analysis revealed that the transcriptional response of the athb1 mutant to MeJA treatment is overall similar to that of wild-type plants. On the contrary, expression of genes involved in JA and SA signaling was observed to be reduced in athb1 with respect to the wild type in the transcriptome comparison of plants grown under normal conditions. Taken together, our results suggest that ATHB1 might influence plant growth under stressful conditions, interacting with different hormone signaling pathways.
2. Materials and Methods
2.1. Plant Materials
The ethylene pathway mutants ein2-1 and etr1-1 were obtained by the Nottingham Arabidopsis Stock Centre (NASC) and are in the Co-0 background.
The athb1-3 allele (line GT6141) was retrieved from the CSHL Ds gene trap collection [20] and is in the Ler background. The insertion had been mapped in the third intron, 995 bp downstream of the ATG, using sequencing of the genomic regions flanking the Ds transposable element. RT-qPCR analysis indicates a reduction, between two- and five-fold, of ATHB1 expression and sequencing of the cDNA indicated the production of an aberrant transcript encoding a truncated ATHB1 protein.
The ATHB1 OE is in the WS background and was obtained by cloning into the pBI101 vector (Clontech, Palo Alto, CA, USA) the fragment, obtained by digestion with EcoRI and XmaI of the total-ATHB1 construct [15], containing the ATHB1 coding sequence preceded by the −343 bp CaMV 35S promoter and followed by the rbcS-E9 terminator. ATHB1 over-expression of about 30-fold was estimated by RT-qPCR.
The ATHB1::GUS reporter is in the WS background and was obtained by cloning a 1870 bp fragment of ATHB1 genomic sequence upstream the translation initiation codon, amplified with ATHB1 5′p (5′-CCCGGGATCCTGCAGCGGAAGAAATACG-3′) and A1C (5′-CGAATTGGATTCCATGGTTGATCAACAG-3′) primers, in frame with the β-glucuronidase (GUS) encoding sequence in the pBI101 vector. This sequence corresponds to the ATHB1 promoter (1500 bp upstream of the transcription start site) and 5′ UTR (370 bp), including the translation regulatory element encoding CPuORF33 [21]. The recombinant plasmid was checked by sequencing to exclude amplification errors.
Standard methods, as described in [22], were used to introduce the binary vectors with the 35S::ATHB1 and ATHB1::GUS recombinant constructs into Agrobacterium tumefaciens strain GV3101 pMP90, for transformation of Arabidopsis plants of the WS ecotype by the vacuum infiltration method and for localization of GUS activity in plant tissues.
2.2. Growth Conditions
After stratification of the seeds for 3–4 d at 4 °C in the dark, Arabidopsis thaliana plants were grown in controlled conditions at 21 °C, under a 16 h light/8 h dark cycle, on GM medium (1× Murashige and Skoog (MS) salts (pH 5.8), 1% sucrose, 0.8% agar) or in soil. For in vitro growth, seeds were surface sterilized as previously described [23].
In order to test ATHB1 expression response to hormones and abiotic stress, Co-0 wild-type 7-day-old seedlings were treated with MeJA as described below while plants grown on soil for 3 weeks were either incubated for 4 h with 1 ppm of ethylene in a closed environment (bell jar), submerged with water for 1, 2 or 4 h (flooding) or cut and incubated in a humid chamber for 1, 2 or 4 h (wounding). After treatment, all samples were collected and immediately frozen in liquid N2 for RNA extraction.
2.3. MeJA Treatment
To test the sensitivity to the hormone, sterile seeds were germinated on GM plates to which equal volumes of a MeJA stock (dissolved in ethanol, final concentration 50 and 100 μM; Duchefa Biochemie, Haarlem, The Netherlands) or ethanol (mock) had been added and observed after 20 days of growth. The experiment was repeated twice with two biological replicates each time.
For microarray expression analysis, 7-day-old seedlings grown on nylon mesh (Nytex 03-100/44, Sefar) in GM plates were transferred to fresh solid medium containing 30 μM MeJA or ethanol (mock). Seedlings were collected after 1 h and 4 h of incubation and immediately frozen in liquid nitrogen for total RNA extraction. The experiment was repeated three times.
2.4. Gene Expression Analysis
Total RNA was isolated using the RNeasy Plant Mini Kit (QIAGEN, Hilden, Germany) following the manufacturer’s protocol, including an on-column DNAse I digestion step to eliminate genomic DNA contamination. For cDNA synthesis, 1 μg of RNA was reverse transcribed using the QuantiTect Reverse Transcription Kit (QIAGEN, Hilden, Germany). RT-qPCR was carried out using SYBR Green PCR Master Mix (Applied Biosystems, Foster City, CA, USA) on an ABI Prism 7900HT (Applied Biosystems, Foster City, CA, USA), in accordance with the manufacturer’s guidelines. Each reaction (10 μL total volume) was performed in 384-well plates and contained 0.5 μL of 1:5 diluted cDNA and 300 nM of each primer. All assays were run in triplicate. Primers were designed with Primer Express Software v2.0 (Applied Biosystems, Foster City, CA, USA) and, whenever feasible, spanned exon–exon junctions to avoid amplification of genomic DNA. The sequences of all primers used, along with the corresponding gene accession numbers, are provided in Supplementary Table S3. Relative gene expression was calculated using the 2−ΔΔCt method, normalizing to ACTIN2 (AT3G18780). Gene expression data for mutants and transgenic lines are shown as log2 fold changes relative to wild type, unless stated otherwise. For each biological replicate, the mean value of three technical replicates was used to determine transcript levels. Unless specified differently, all the RT-qPCR results represent the average of three independent biological replicates, and standard deviations (SD) were calculated using the method recommended by [24].
2.5. Microarray Analysis
Total RNA, extracted from three independent experimental replicates of WT (Ler) and athb1-3 seedlings treated with MeJA (or mock) for 1 h and 4 h as described above, was hybridized to Affymetrix Gene-1-1-ST Arabidopsis Array Plate by the NASC Affymetrix Service (https://arabidopsis.info/affy/link_to_iplant.html; accessed on 9 September 2025). For the statistical analysis of the 24 microarray samples, raw signal intensities were normalized using the GCRMA method, which incorporates probe GC content into the Robust Multiarray Analysis algorithm. Quality control of the data was assessed through NUSE and RLE plots. Additionally, to evaluate the similarity of gene expression profiles under different conditions, we performed principal component analysis (PCA) and hierarchical clustering of the normalized datasets. The Limma R-package v2.16.0 [25] was used for statistical analysis. By using linear data model, empirical Bayes-moderated t-statistics were computed for each biological comparison, selecting as significantly differentially expressed only the probes with a p-value adjusted with Benjamini–Hochberg false discovery rate (FDR) test lower than 0.05. Differentially expressed probes were annotated to Arabidopsis genes using the NetAffx utility available on Affymetrix website. All microarray data of this study were deposited in the NASCArray database (http://bar.utoronto.ca/NASCArrays/index.php?ExpID=572; accessed on 9 September 2025). To validate the array results, gene expression of selected genes was tested by RT-qPCR. GO term enrichment was analyzed with PANTHER Overrepresentation Test (Released 20240226) version 18.0 (https://www.pantherdb.org/; accessed on 9 September 2025) using default parameters (GO Ontology database Released 17 January 2024 https://zenodo.org/records/10536401; accessed on 9 September 2025). Enrichment significance was calculated by means of Fisher’s Exact test and p-values were adjusted for multiple testing using Benjamini–Hochberg FDR. Heatmap representation and clustering of differential gene expression were created in R using the Pheatmap package [26]. Promoter sequences (3000 bp upstream of translation start site) of the DEGs were retrieved from the genome of A. thaliana using TAIR or RSAT Plant tools (https://rsat.eead.csic.es/plants/retrieve-seq_form.cgi; accessed on 9 September 2025). RSAT Plant was used for scanning the ATHB1 binding site in the promoter regions [27].
3. Results
3.1. ATHB1 Expression Is Stress Inducible and Regulated by Ethylene
To explore ATHB1 involvement in the response to adverse environmental conditions, we first analyzed ATHB1 expression after flooding and wounding of the plants. We found that both treatments increase the ATHB1 transcript (Figure 1A), suggesting that ATHB1 could take part in the plant response to these stresses.

Figure 1.
RT-qPCR analysis of ATHB1 expression. RNA was extracted from: (A,B) leaves of 3-week-old WT (Co-0) plants submerged (flood) or wounded (wound) for the indicated time or treated 4 h with 1 ppm ethylene; (C) 2-week-old seedlings (juvenile) and leaves of WT, ein2-1 and etr1-1 plants in two adult stages (bolting and flowering); (D) 1-week-old WT seedlings treated 1 h with 30 µM MeJA. Values are mean ± SD (technical triplicates) of relative quantification (2−ΔΔCt) with respect to untreated plants (A,B,D) or to 2-week-old WT seedlings (C) * p < 0.05 ** p < 0.01 (Student’s t-test). Different letters above the columns indicate statistically significant differences p < 0.05 (one-way ANOVA; Tukey test). ACTIN2 was used as reference gene for normalization.
By promoter-GUS analysis, we noticed that ATHB1 expression increased with leaf age (Supplementary Figure S1A), in agreement with expression data reported in the BAR repository of the University of Toronto (https://bar.utoronto.ca; accessed on 9 September 2025) and in [28]. In flowers, GUS staining was observed in the stigma, stamen filaments and in the floral organ abscission zone at the base of developing siliques (Supplementary Figure S1B). It is known that ethylene signaling plays a key role in abiotic and biotic stress responses, leaf development, and in senescence and abscission of vegetative and floral organs [28,29,30]. Intriguingly, we observed that exogenous addition of ethylene increases ATHB1 mRNA accumulation (Figure 1B), further confirming that this hormone is a positive regulator of ATHB1 expression [18].
To investigate the link between ATHB1 and ethylene during leaf maturation, we analyzed ATHB1 expression in ethylene signaling mutants at different phases of growth. A reduction in the steady-state level of ATHB1 mRNA was clearly observed in both ein2-1 and etr1-1 ethylene-insensitive mutants (Figure 1C). Nonetheless, age-dependent accumulation of the ATHB1 transcript was still observed in the two mutants, indicating that ATHB1 regulation is controlled by both ethylene and developmental signals.
3.2. ATHB1 Enhances Sensitivity to MeJA Treatment
It has been reported that ethylene acts both synergistically and antagonistically with JA signaling to regulate plant defense and growth under unfavorable environmental conditions [4,31,32]; moreover, it has been shown that the expression of several key response genes conferring biotic and abiotic stress tolerance is induced by both ethylene and the JA signaling pathway [4,6,31,32]. The enhancement of JA production by wound, cold, drought, salinity and other stress conditions has profound physiological consequences and serves as a signaling mechanism, particularly for systemic spreading of wound response [33,34,35].
To evaluate a possible interaction between ATHB1 and JA signaling, we first analyzed ATHB1 transcript level in WT seedlings exposed to 30 μM MeJA and observed a negative regulation of ATHB1 expression (Figure 1D). Then, we analyzed the effect of reduced and increased ATHB1 expression (athb1-3 mutant and ATHB1 OE plants, Supplementary Figure S2) on plant sensitivity to exogenous application of MeJA during vegetative development.
When seeds were germinated on plates containing 50 μM or 100 μM MeJA, the growth of wild-type, athb1-3 and ATHB1 OE plants was impaired in a dose-dependent manner (Figure 2). Nonetheless, while the athb1-3 mutant plants were less affected, the ATHB1 OE plants were smaller and arrested in their growth, clearly indicating that they are more affected than the parental wild type (Figure 2). This opposite behavior of plants with reduced or increased levels of ATHB1 upon MeJA application suggests that this transcription factor interacts with the JA signaling pathway and influences hormone sensitivity/response downstream of JA.
Figure 2.
Differential response of ATHB1 OE and athb1 plants to exogenous MeJA application. WT, athb1-3 and ATHB1 OE seedlings were grown on plates containing 50 µM or 100 µM MeJA or mock and photographed after 20 days.
3.3. ATHB1 Affects the Expression of Genes Responsive to MeJA Treatment
To understand how ATHB1 affects sensitivity to MeJA treatment in Arabidopsis, a microarray transcriptomic analysis was performed comparing RNA from 7-day-old WT and athb1-3 mutant seedlings exposed to MeJA or mock-treated for 1 and 4 h. Surprisingly, only seven genes resulted to be differentially regulated (log2FC > 1) with statistical significance (p-value < 0.05) in the two genotypes after 4 h of MeJA application, and none after 1 h of treatment (Table 1). Nonetheless, it is noteworthy that all these genes encode regulatory proteins (ZAT10, NAC36, JAZ5, VQ10) or proteins involved in hormone signal transduction (CML38, EDS5, NATA1).

Table 1.
List of genes differentially expressed in microarray in the comparison (athb1 MeJA/mock)—(WT MeJA/mock) 4 h after MeJA application and expression of the selected genes in untreated athb1 respect to WT (1 h and 4 h mock).
By looking at the expression of these genes in untreated samples, we observed that almost all were already differentially expressed in the mutant background before MeJA application, while hormone response was similar in the two genotypes. Therefore, we then compared mock-treated WT and athb1 samples (1 h and 4 h, in triplicate) and found a set of 119 statistically significantly, differentially expressed genes (DEGs, log2FC > 0.5), plus ATHB1 itself (Supplementary Table S1). This gene set is enriched in both abiotic and biotic stress response pathways. Among these genes potentially acting downstream of ATHB1, 40 are upregulated in the athb1 mutant, while the majority (79) are downregulated (Figure 3A), in agreement with the reported transcription activation function of ATHB1 [15].

Figure 3.
(A) Differentially expressed genes (DEGs) between WT and athb1 mutant. The comparison included triplicate samples of each genotype at two time points (1 and 4 h) after mock treatment. Numbers refer to DEGs, and up and down arrows indicate higher or lower expression, respectively, in athb1. (B) Gene Ontology (GO) term enrichment of downregulated genes in athb1 with respect to WT plants. The reported enriched terms represent the most specific subclasses from the same parent term. The length of the bars represents the fold enrichment of the GO term occurrence in the sample with respect to the background (whole genome). The statistical significance (FDR) of the over-representation is indicated at the end of the bar. (C) Heatmap depicting the expression patterns of differentially expressed genes in athb1 with respect to WT-untreated seedlings (athb1/WT mock 1 h and 4 h) in response to MeJA application in both genotypes upon 1 h or 4 h treatment. Three biological replicates were used for each time point. Hierarchical clustering and identity of the samples are reported on top and bottom of the columns, respectively. Gene expression clusters are indicated to the right, while AGI codes of genes are on the left. The color scale represents relative expression values (log2FC) of microarray analysis, with relatively higher and lower expression levels indicated in orange and blue, respectively. Grey indicates no change upon stimulation.
To gain further information about the genes differentially regulated in athb1, the upregulated and downregulated transcripts were separately categorized for gene ontologies (GO). Non-redundant significant over-represented terms in the GO Biological Process (BP) category were identified for downregulated genes (Figure 3B), while no enriched terms were detected for the upregulated ones. The complete list of enriched GO terms is reported in Supplementary Table S2. In agreement with the altered sensitivity to MeJA treatment of athb1, the GO terms “induced systemic resistance, jasmonic acid mediated signaling pathway”, “regulation of jasmonic acid mediated signaling pathway” and “systemic acquired resistance” are among the most strongly enriched, together with other GO terms related to “defense response” and “response to biotic stimulus” such as “salicylic acid mediated signaling pathway”, “response to oomycetes” and “defense response to fungus”. In addition, significant enrichment was found for the GO terms “cellular response to hypoxia”, “response to wounding”, “response to oxidative stress”, “response to inorganic substance” and others related to “response to stress” and “response to abiotic stimulus”, thus confirming the interaction of ATHB1 with the stress signaling regulatory networks.
Interestingly, many of the genes downregulated in athb1 encode transcription factors. Two of them, JASMONATE ZIM-DOMAIN 1 (JAZ1) and JAZ5, encode nuclear transcriptional repressors directly linked to JA response [36]. WRKY40 and WRKY70 are involved in integrating the antagonistic effects of JA and SA on defense-related gene expression regulation [37,38,39]. NAC90 and NAC36 are members of the NO APICAL MERISTEM/ARABIDOPSIS TRANSCRIPTION INITIATION FACTOR/CUP-SHAPED COTYLEDON (NAC) family of plant TF that include many regulators of leaf senescence [40]. The ZAT10 and ZAT12 genes, encoding C2H2 zinc finger transcription factors containing an EAR suppressor domain, respond to a large number of stress conditions and are considered abiotic stress markers [41]. Finally, ERF2 (ETHYLENE RESPONSE FACTOR 2) encodes an APETALA2 (AP2)/ERF TF, whose expression is altered after MeJA treatment, that has been shown to positively regulate JA-responsive defense genes and enhance JA-dependent inhibition of root elongation [42]. Besides TFs, among genes downregulated in athb1, we also found genes involved in JA and SA synthesis. For example, LOX4 encodes one of the four 13-lipoxygenases (13-LOXs) that produce JA precursors in aerial tissues in Arabidopsis [43]. ENHANCED DISEASE SUSCEPTIBILITY 1 (EDS1) encodes an SA-induced transcriptional cofactor that positively regulates the SA biosynthesis gene ICS1 (ISOCHORISMATE SYNTHASE1), forming a positive feedback loop that enhances SA response [44]. ENHANCED DISEASE SUSCEPTIBILITY 5 (EDS5), whose expression is regulated by SA and JA, encodes a transporter necessary for the export of isochorismate from chloroplasts to the cytoplasm [45]. In addition, other genes are involved in JA and SA signaling like GRX480 (GLUTAREDOXIN480, also known as ROXY19) [46], AT2G32140 (TIR-X), encoding a protein with a TIR (Toll/interleukin-1 receptor) domain [47], the JA and wound response marker TYROSINE AMINOTRANSFERASE 3 (TAT3) [48], the SA induced aspartyl protease encoded by APOPLASTIC, EDS1-DEPENDENT 1 (AED1) [49], the WRKY70 target LATE UPREGULATED IN RESPONSE TO Hyaloperonospora parasitica 1 (LURP1) [50], the ubiquitin 26S proteasome system substrate adaptor protein F-BOX STRESS-INDUCED 1 (FBS1) [51] and the MITOGEN-ACTIVATED PROTEIN KINASE KINASE 4 (MKK4) required for the SA-promoted leaf senescence [52]. Finally, several genes encoding CALMODULIN-LIKE (CMLs, CML10, CML38, CML44, CML46) involved in Ca2+ sensing [53] and CALCIUM-DEPENDENT PROTEIN KINASE 29 (CPK29) that interprets Ca2+ signals from internal and external triggers [54] are also found. In particular, CML38 is acutely induced early in hypoxia and is a signaling hub during low oxygen stress in A. thaliana [53]. Amongst the genes whose expression is increased in athb1, we found FLOWERING LOCUS C (FLC) and 1-AMINO-CYCLOPROPANE-1-CARBOXYLIC ACID (ACC) OXIDASE 3 (ACO3). FLC encodes a MADS box TF that is a central flowering regulator in Arabidopsis integrating vernalization and autonomous pathways [55]. ACO3 encodes an enzymatic protein that converts ACC to ethylene, particularly involved in ethylene biosynthesis in the root [56].
To further explore the interactions between ATHB1 and JA signaling, we compared the 119 differentially regulated genes in athb1 relative to WT under basal conditions with the two datasets of differentially regulated genes in the WT 1 h and 4 h after MeJA application. We found that expression of about 50% of the genes differentially expressed in athb1 with respect to WT respond to MeJA treatment, and about 20% of them show differential expression at both time points (Figure 3C). Genes induced and repressed by MeJA treatment are almost equally present and include genes encoding transcription factors (JAZ1, JAZ5, NAC36, WRKY40, ERF2, ZAT10, ZAT12) and proteins involved in JA response (LOX4, TAT3, TIR-X, GRX480). Hierarchical clustering of DEGs profiles in WT and athb1 after MeJA application confirms that the transcriptional response to the hormone is not substantially affected in the mutant, as previously shown by the analysis of the whole transcriptome (Table 1). A set of 15 genes differentially regulated in athb1 relative to WT (2 upregulated and 13 downregulated) was chosen to validate the results of the microarray by RT-qPCR analysis. The results, shown in Table 2, indicate a good correlation between log2FC values obtained using RT-qPCR and RNA microarray, demonstrating data reliability.

Table 2.
RT-qPCR validation of microarray results for 15 genes differentially expressed in athb1 seedlings compared with WT (mock treated 4 h).
ATHB1 binds the pseudo palindromic sequence CAAT(A/T)ATTG (BS-I site) in vitro [57,58,59] and in transient expression experiments [15]. Therefore, we investigated which of the genes whose transcript level was altered in the athb1 mutant background have this target sequence in the promoter region by analyzing their 5′ upstream sequences deposited in Arabidopsis databases. Considering that the lateral positions may have greater variability [57], we first scanned the promoter sequences of the differentially expressed genes for the presence of BS-I site core AAT(A/T)ATT and found that this motif is present at least once in 87% of the DEGs (Supplementary Table S1). Among these, four genes exhibited the full, nine bp-long ATHB1 binding site in the 3000 bp preceding the transcription start site (Supplementary Table S1).
4. Discussion
Plant growth exhibits remarkable plasticity, enabling adaptation of the intrinsic developmental program to varying and often challenging environmental conditions. This flexibility is largely mediated by the intricate interaction between hormonal signaling pathways and transcriptional regulation. Among the various TF families involved, the HD-ZIP I family, to which ATHB1 belongs, stands out for its potential in crop improvement, as some of these TFs have been shown to influence key developmental processes and to respond to hormone signals and biotic and abiotic stresses [7,13,60,61,62]. In particular, data in the literature indicate that ATHB1 controls hypocotyl elongation under short-day regimes [17] and affects leaf cell expansion [15] and leaf margin serration through direct repression of miR164 and regulation of CUC2 expression [16]. Furthermore, ATHB1 expression was found to be regulated negatively by ABA, salt and cold stress [7], positively by ethylene [18] and oppositely by drought in plants cultured in vitro [7], or grown in soil [12]. In addition, mining of the BAR repository for expression data of HD-Zip members in abiotic stress experiments highlighted that, in roots, ATHB1 was induced by osmotic, genotoxic, UV-B, and high-temperature conditions, whereas it was slightly repressed by sodium chloride [60]. In this study, we demonstrated that ATHB1 is also induced by other stresses, namely flooding and wounding. Moreover, we found that, in leaves, ATHB1 expression is affected by the ethylene signal transduction pathway, being reduced in ein-2 and etr-1 mutants. However, an age-dependent increase of the ATHB1 transcript level is still observed in these mutants, suggesting that the gene is also under developmental control. Several studies have indicated that ethylene can act in a coordinated or antagonistic manner with JA to regulate plant defense against stress, and cross-regulation of the two signaling pathways can occur through convergence on key TFs that confer abiotic stress tolerance, such as ethylene response factors (ERFs) [4,31,32]. Integration of the JA and ethylene signaling pathways has also been reported for an HD-ZIP I TF through the functional analysis of transgenic Arabidopsis and maize plants constitutively expressing the sunflower HaHB4 gene [63]. In addition, analysis of the genes resulting from the transcriptome comparison of Arabidopsis thaliana plants over-expressing HD-Zip I proteins linked to water deficit tolerance have pointed out hormone responses (jasmonic acid, salicylic acid, ethylene, gibberellin and ABA) and biotic and abiotic stresses (defense response and water deprivation) among the enriched GO terms and the ethylene-related pathway as the most relevant in co-expression analysis [12]. Although JA signaling contributes to stress tolerance, the application of MeJA during vegetative development generally impairs plant growth [48,64,65]. By growing plants in the presence of MeJA, we found that growth inhibition is influenced by the level of ATHB1 expression, with sensitivity decreasing in athb1 plants and increasing in ATHB1 OE plants compared to WT plants. Despite this physiological evidence, a comprehensive gene expression analysis using microarray revealed that the transcriptional response is not significantly affected by MEJA treatment in the athb1 mutant. In fact, only seven genes were found to be differentially expressed in the mutant compared to WT plants after 4 h of MeJA treatment, and none after 1 h. Notably, we observed that this differential regulation was likely due to different baseline expression levels in untreated WT and athb1 plants rather than a distinct response of the two genotypes to hormone application. Analysis of the untreated samples allowed us to identify 119 high-confidence DEGs that are potentially regulated by ATHB1. The majority (79) of these DEGs are downregulated, while only about one-third (40) are upregulated in the mutant background. Interestingly, enrichment analysis reveals that GO terms associated with JA signaling and response are significantly enriched among the downregulated genes. In addition, about half of the DEGs respond to MeJA treatment in both WT and athb1 seedlings, suggesting that ATHB1 influences the basal expression of genes affected by the JA signaling, although it is not essential for their response following MeJA application. Thus, the reduced expression levels of transcription factors (JAZ1, JAZ5, WRKY40, ERF2, ZAT10) and proteins (LOX4, TAT3, TIR-X, GRX480) involved in JA signaling in untreated plants may explain the decreased sensitivity of athb1 plants to MeJA application.
Interestingly, among the downregulated genes in the athb1 mutant, there are also important regulators of the SA-mediated response. For instance, NAC90 is part of a “NAC troika” shown to regulate genes involved in SA synthesis and downstream TFs of SA signaling, including WRKY40 and WRKY70, whose expression is also affected in athb1 [66]. Specifically, NAC90 has been identified as a negative regulator of SA-mediated leaf senescence, directly binding and suppressing promoters of target genes, including EDS5 [66], which is also downregulated in athb1. This leads to a reduction of SA accumulation at the pre-senescent stage [66]. Another “NAC triad”, including both NAC90 and NAC36, was recently shown to negatively regulate plant immunity by directly repressing expression of N-hydroxy pipecolic acid and SA biosynthetic genes [67]. As transcription of both NAC90 and NAC36 is induced by SA, a negative feedback loop is established upon pathogen infections to prevent excessive SA accumulation, early senescence and growth inhibition [67]. WRKY40 and WRKY70 encode proteins belonging to the WRKY family, the largest and most extensively studied group of plant TFs involved in biotic and abiotic stress responses and adaptation [68]. It is important to emphasize that WRKY TFs often act in concert with proteins of the VQ motif-containing family of plant-specific transcriptional regulators [69] and one member of this group, VQ10, is also found to be downregulated in the athb1 mutant. Notably, WRKY70 expression is responsive to reactive oxygen species and shows interesting similarities with ATHB1 regarding tissue specificity, being present in both stigmatic papillae and the flower abscission zone [70], as well as in leaves, where its level gradually increases with leaf senescence [70,71]. Finally, it is worth mentioning EDS1 and GRX480, encoding two transcriptional cofactors induced by SA and acting negatively on promoters of JA-responsive genes, thus participating in SA/JA crosstalk [44,46].
Overall, our data suggest that ATHB1, whose expression is regulated during plant growth and development, as well as by ethylene and JA, may interact with transcriptional regulatory networks mediating ethylene-, JA- and SA-dependent stress responses (Figure 4). Depending on the cell type, developmental stage, and growth conditions, ATHB1 activity—also regulated at post-transcriptional levels through CpuORF33 [21]—may influence the production of molecules involved in stress signal perception and transduction by modulating stress-responsive TFs and their targets. This regulatory network may establish a specific basal physiological state, which, in turn, affects the amplitude of the defense response and the organism’s ability to adapt and survive under unfavorable and stressful conditions.

Figure 4.
The model illustrates the interaction of ATHB1 with hormone-dependent transcriptional regulatory networks, revealed by this study, and the proposed role of ATHB1 in the integration of developmental and stress signals affecting the growth-defense balance under unfavorable environmental conditions. DEGs related to hormone signaling are colored in lilac (ethylene, ET), orange (JA) or cyan (SA). Proteins involved in hormone synthesis or signaling are represented as ovals, TFs as rectangles and effector proteins as hexagons.
5. Conclusions
The data presented in this study, along with findings from the literature, suggest that ATHB1 functionally interacts with key regulators of plant growth and development (e.g., light, hormones) as well as abiotic and biotic stress responses. Further studies are needed to explore how the interplay between ATHB1 and signaling pathways can be exploited, including in relevant crops, to enhance plant growth and productivity under various stress conditions. This could help maximize the activation of acclimation and defense pathways while minimizing negative pleiotropic effects on growth and yield.
Supplementary Materials
The following supporting information can be downloaded at: https://www.mdpi.com/article/10.3390/cells14181456/s1. Figure S1: Histochemical localization of GUS activity in transgenic ATHB1::GUS seedlings; Figure S2: Phenotype of athb1-3 mutant and ATHB1 OE plants [16]; Table S1: List of differentially expressed genes in athb1 with respect to WT seedlings; Table S2: List of GO Biological Process (BP) category; Table S3: List of primers.
Author Contributions
V.F., S.L., B.F., S.B. and M.P. performed the experiments; A.C. performed the bioinformatic analysis; V.F., S.L., S.B. and G.M. analyzed the data; G.M. and S.B. supervised the project; S.B. drafted the manuscript; G.M. and F.D. contributed to the writing and revised the manuscript. All authors have read and agreed to the published version of the manuscript.
Funding
This research was funded by POR FESR LAZIO 2014–2020, SMART-BREED Project grant number A0375E0166 and by the National Research Center for Agricultural Technologies (Agritech), European Union Next-Generation EU, grant PNRR CN00000022.
Institutional Review Board Statement
Not applicable.
Informed Consent Statement
Not applicable.
Data Availability Statement
All data and materials presented in this paper are available on request from the corresponding author. Data supporting the reported results are available in a publicly accessible repository as NASCarrays experiment no. 572, release date 24 May 2012 and can be found at The BAR (http://bar.utoronto.ca/NASCArrays/index.php?ExpID=572; accessed on 9 September 2025).
Acknowledgments
We dedicate this article to the memory of Ida Ruberti, whose inspiration guided our exploration of the role of HD-ZIP factors in development and stress responses. We thank NASC for the ein2-1 and etr1-1 seeds and the REGIA consortium (EU grant QLG2-1999-00876) for providing the GT6141 line seeds. We thank Federico Gaetano Chionchio and Kariklia Pascucci for helping with the daily laboratory routine.
Conflicts of Interest
The authors declare no conflicts of interest. The funders had no role in the design of the study; the collection, analyses, or interpretation of data; the writing of the manuscript; or the decision to publish the results.
References
- Zhang, H.; Zhu, J.; Gong, Z.; Zhu, J.-K. Abiotic stress responses in plants. Nat. Rev. Genet. 2022, 23, 104–119. [Google Scholar] [CrossRef]
- Aerts, N.; Pereira Mendes, M.; Van Wees, S.C.M. Multiple levels of crosstalk in hormone networks regulating plant defense. Plant J. 2021, 105, 489–504. [Google Scholar] [CrossRef] [PubMed]
- Waadt, R.; Seller, C.A.; Hsu, P.-K.; Takahashi, Y.; Munemasa, S.; Schroeder, J.I. Plant hormone regulation of abiotic stress responses. Nat. Rev. Mol. Cell Biol. 2022, 23, 680–694. [Google Scholar] [CrossRef]
- Kazan, K. Diverse roles of jasmonates and ethylene in abiotic stress tolerance. Trends Plant Sci. 2015, 20, 219–229. [Google Scholar] [CrossRef]
- Khan, S.-A.; Li, M.-Z.; Wang, S.-M.; Yin, H.-J. Revisiting the Role of Plant Transcription Factors in the Battle against Abiotic Stress. Int. J. Mol. Sci. 2018, 19, 1634. [Google Scholar] [CrossRef]
- Yin, L.; Zander, M.; Carol Huang, S.; Xie, M.; Paola Saldierna Guzmán, J.; Hann, E.; Shanbhag, B.K.; Ng, S.; Jain, S.; Janssen, B.J.; et al. Transcription Factor Dynamics in Cross-Regulation of Plant Hormone Signaling Pathways. bioRxiv 2023. [Google Scholar] [CrossRef]
- Henriksson, E.; Olsson, A.S.B.; Johannesson, H.; Johansson, H.; Hanson, J.; Engström, P.; SödErman, E. Homeodomain Leucine Zipper Class I Genes in Arabidopsis. Expression Patterns and Phylogenetic Relationships. Plant Physiol. 2005, 139, 509–518. [Google Scholar] [CrossRef]
- Dezar, C.A.; Gago, G.M.; González, D.H.; Chan, R.L. Hahb-4, a sunflower homeobox-leucine zipper gene, is a developmental regulator and confers drought tolerance to Arabidopsis thaliana plants. Transgenic Res. 2005, 14, 429–440. [Google Scholar] [CrossRef]
- Deng, X.; Phillips, J.; Bräutigam, A.; Engström, P.; Johannesson, H.; Ouwerkerk, P.B.F.; Ruberti, I.; Salinas, J.; Vera, P.; Iannacone, R.; et al. A Homeodomain Leucine Zipper Gene from Craterostigma plantagineum Regulates Abscisic Acid Responsive Gene Expression and Physiological Responses. Plant Mol. Biol. 2006, 61, 469–489. [Google Scholar] [CrossRef]
- Agalou, A.; Purwantomo, S.; Övernäs, E.; Johannesson, H.; Zhu, X.; Estiati, A.; de Kam, R.J.; Engström, P.; Slamet-Loedin, I.H.; Zhu, Z.; et al. A genome-wide survey of HD-Zip genes in rice and analysis of drought-responsive family members. Plant Mol. Biol. 2008, 66, 87–103. [Google Scholar] [CrossRef] [PubMed]
- Shen, W.; Li, H.; Teng, R.; Wang, Y.; Wang, W.; Zhuang, J. Genomic and transcriptomic analyses of HD-Zip family transcription factors and their responses to abiotic stress in tea plant (Camellia sinensis). Genomics 2019, 111, 1142–1151. [Google Scholar] [CrossRef]
- Romani, F.; Ribone, P.A.; Capella, M.; Miguel, V.N.; Chan, R.L. A matter of quantity: Common features in the drought response of transgenic plants overexpressing HD-Zip I transcription factors. Plant Sci. 2016, 251, 139–154. [Google Scholar] [CrossRef]
- Perotti, M.F.; Ribone, P.A.; Chan, R.L. Plant transcription factors from the homeodomain-leucine zipper family I. Role in development and stress responses. IUBMB Life 2017, 69, 280–289. [Google Scholar] [CrossRef]
- Ruberti, I.; Sessa, G.; Lucchetti, S.; Morelli, G. A novel class of plant proteins containing a homeodomain with a closely linked leucine zipper motif. EMBO J. 1991, 10, 1787–1791. [Google Scholar] [CrossRef]
- Aoyama, T.; Dong, C.-H.; Wu, Y.; Carabelli, M.; Sessa, G.; Ruberti, I.; Morelli, G.; Chua, N.-H. Ectopic Expression of the Arabidopsis Transcriptional Activator Athb-I Alters Leaf Cell Fate in Tobacco. Plant Cell 1995, 7, 1773–1785. [Google Scholar] [PubMed]
- Miguel, V.N.; Manavella, P.A.; Chan, R.L.; Capella, M. The AtHB1 Transcription Factor Controls the miR164-CUC2 Regulatory Node to Modulate Leaf Development. Plant Cell Physiol. 2020, 61, 659–670. [Google Scholar] [CrossRef]
- Capella, M.; Ribone, P.A.; Arce, A.L.; Chan, R.L. Arabidopsis thaliana HomeoBox 1 (AtHB1), a Homedomain-Leucine Zipper I (HD-Zip I) transcription factor, is regulated by PHYTOCHROME-INTERACTING FACTOR 1 to promote hypocotyl elongation. New Phytol. 2015, 207, 669–682. [Google Scholar] [CrossRef] [PubMed]
- Zhong, G.Y.; Burns, J.K. Profiling ethylene-regulated gene expression in Arabidopsis thaliana by microarray analysis. Plant Mol. Biol. 2003, 53, 117–131. [Google Scholar] [CrossRef] [PubMed]
- Lin, Z.; Hong, Y.; Yin, M.; Li, C.; Zhang, K.; Grierson, D. A tomato HD-Zip homeobox protein, LeHB-1, plays an important role in floral organogenesis and ripening. Plant J. 2008, 55, 301–310. [Google Scholar] [CrossRef]
- Sundaresan, V.; Springer, P.; Volpe, T.; Haward, S.; Jones, J.D.; Dean, C.; Ma, H.; Martienssen, R. Patterns of gene action in plant development revealed by enhancer trap and gene trap transposable elements. Genes Dev. 1995, 9, 1797–1810. [Google Scholar] [CrossRef]
- Ribone, P.A.; Capella, M.; Arce, A.L.; Chan, R.L. A uORF Represses the Transcription Factor AtHB1 in Aerial Tissues to Avoid a Deleterious Phenotype. Plant Physiol. 2017, 175, 1238–1253. [Google Scholar] [CrossRef] [PubMed]
- Baima, S.; Nobili, F.; Sessa, G.; Lucchetti, S.; Ruberti, I.; Morelli, G. The expression of the Athb-8 homeobox gene is restricted to provascular cells in Arabidopsis thaliana. Development 1995, 121, 4171–4182. [Google Scholar] [CrossRef]
- Baima, S.; Possenti, M.; Matteucci, A.; Wisman, E.; Altamura, M.M.; Ruberti, I.; Morelli, G. The arabidopsis ATHB-8 HD-zip protein acts as a differentiation-promoting transcription factor of the vascular meristems. Plant Physiol. 2001, 126, 643–655. [Google Scholar] [CrossRef] [PubMed]
- Willems, E.; Leyns, L.; Vandesompele, J. Standardization of real-time PCR gene expression data from independent biological replicates. Anal. Biochem. 2008, 379, 127–129. [Google Scholar] [CrossRef] [PubMed]
- Smyth, G.K. Linear Models and Empirical Bayes Methods for Assessing Differential Expression in Microarray Experiments. Stat. Appl. Genet. Mol. Biol. 2004, 3, 1–25. [Google Scholar] [CrossRef]
- Kolde, R. Pheatmap: Pretty Heatmaps. R Package Version 1.0.12. 2019. Available online: https://CRAN.R-project.org/package=pheatmap (accessed on 9 September 2025).
- Santana-Garcia, W.; Castro-Mondragon, J.A.; Padilla-Gálvez, M.; Nguyen, N.T.T.; Elizondo-Salas, A.; Ksouri, N.; Gerbes, F.; Thieffry, D.; Vincens, P.; Contreras-Moreira, B.; et al. RSAT 2022: Regulatory sequence analysis tools. Nucleic Acids Res. 2022, 50, W670–W676. [Google Scholar] [CrossRef]
- Graham, L.E.; Schippers, J.H.M.; Dijkwel, P.P.; Wagstaff, C. Ethylene and Senescence Processes. In Annual Plant Reviews Volume 44: The Plant Hormone Ethylene; Wiley: Hoboken, NJ, USA, 2012; pp. 305–341. [Google Scholar]
- Patterson, S.E.; Bleecker, A.B. Ethylene-Dependent and-Independent Processes Associated with Floral Organ Abscission in Arabidopsis. Plant Physiol. 2004, 134, 194–203. [Google Scholar] [CrossRef]
- Roberts, J.A.; Whitelaw, C.A.; Gonzalez-Carranza, Z.H.; McManus, M.T. Cell Separation Processes in Plants–Models, Mechanisms and Manipulation. Ann. Bot. 2000, 86, 223–235. [Google Scholar] [CrossRef]
- Zhu, Z. Molecular basis for jasmonate and ethylene signal interactions in Arabidopsis. J. Exp. Bot. 2014, 65, 5743–5748. [Google Scholar] [CrossRef]
- Pérez-Llorca, M.; Pollmann, S.; Müller, M. Ethylene and Jasmonates Signaling Network Mediating Secondary Metabolites under Abiotic Stress. Int. J. Mol. Sci. 2023, 24, 5990. [Google Scholar] [CrossRef]
- Farhangi-Abriz, S.; Ghassemi-Golezani, K. Jasmonates: Mechanisms and functions in abiotic stress tolerance of plants. Biocatal. Agric. Biotechnol. 2019, 20, 101210. [Google Scholar] [CrossRef]
- Wang, J.; Song, L.; Gong, X.; Xu, J.; Li, M. Functions of Jasmonic Acid in Plant Regulation and Response to Abiotic Stress. Int. J. Mol. Sci. 2020, 21, 1446. [Google Scholar] [CrossRef]
- Raza, A.; Charagh, S.; Zahid, Z.; Mubarik, M.S.; Javed, R.; Siddiqui, M.H.; Hasanuzzaman, M. Jasmonic acid: A key frontier in conferring abiotic stress tolerance in plants. Plant Cell Rep. 2021, 40, 1513–1541. [Google Scholar] [CrossRef]
- Hu, S.; Yu, K.; Yan, J.; Shan, X.; Xie, D. Jasmonate perception: Ligand–receptor interaction, regulation, and evolution. Mol. Plant 2023, 16, 23–42. [Google Scholar] [CrossRef] [PubMed]
- Li, J.; Brader, G.; Palva, E.T. The WRKY70 Transcription Factor: A Node of Convergence for Jasmonate-Mediated and Salicylate-Mediated Signals in Plant Defense. Plant Cell 2004, 16, 319–331. [Google Scholar] [CrossRef]
- Brotman, Y.; Landau, U.; Cuadros-Inostroza, Á.; Takayuki, T.; Fernie, A.R.; Chet, I.; Viterbo, A.; Willmitzer, L. Trichoderma-Plant Root Colonization: Escaping Early Plant Defense Responses and Activation of the Antioxidant Machinery for Saline Stress Tolerance. PLoS Pathog. 2013, 9, e1003221. [Google Scholar] [CrossRef]
- Kroes, A.; van Loon, J.J.A.; Dicke, M. Density-Dependent Interference of Aphids with Caterpillar-Induced Defenses in Arabidopsis: Involvement of Phytohormones and Transcription Factors. Plant Cell Physiol. 2015, 56, 98–106. [Google Scholar] [CrossRef]
- Kim, H.J.; Nam, H.G.; Lim, P.O. Regulatory network of NAC transcription factors in leaf senescence. Curr. Opin. Plant Biol. 2016, 33, 48–56. [Google Scholar] [CrossRef]
- Xie, M.; Sun, J.; Gong, D.; Kong, Y. The Roles of Arabidopsis C1-2i Subclass of C2H2-type Zinc-Finger Transcription Factors. Genes 2019, 10, 653. [Google Scholar] [CrossRef]
- McGrath, K.C.; Dombrecht, B.; Manners, J.M.; Schenk, P.M.; Edgar, C.I.; Maclean, D.J.; Scheible, W.-R.; Udvardi, M.K.; Kazan, K. Repressor- and Activator-Type Ethylene Response Factors Functioning in Jasmonate Signaling and Disease Resistance Identified via a Genome-Wide Screen of Arabidopsis Transcription Factor Gene Expression. Plant Physiol. 2005, 139, 949–959. [Google Scholar] [CrossRef]
- Yang, T.-H.; Lenglet-Hilfiker, A.; Stolz, S.; Glauser, G.; Farmer, E.E. Jasmonate Precursor Biosynthetic Enzymes LOX3 and LOX4 Control Wound-Response Growth Restriction. Plant Physiol. 2020, 184, 1172–1180. [Google Scholar] [CrossRef] [PubMed]
- Khan, M.S.S.; Islam, F.; Chen, H.; Chang, M.; Wang, D.; Liu, F.; Fu, Z.Q.; Chen, J. Transcriptional Coactivators: Driving Force of Plant Immunity. Front. Plant Sci. 2022, 13, 823937. [Google Scholar] [CrossRef]
- Mine, A.; Nobori, T.; Salazar-Rondon, M.C.; Winkelmüller, T.M.; Anver, S.; Becker, D.; Tsuda, K. An incoherent feed-forward loop mediates robustness and tunability in a plant immune network. EMBO Rep. 2017, 18, 464–476. [Google Scholar] [CrossRef]
- Uhrig, J.F.; Huang, L.-J.; Barghahn, S.; Willmer, M.; Thurow, C.; Gatz, C. CC-type glutaredoxins recruit the transcriptional co-repressor TOPLESS to TGA-dependent target promoters in Arabidopsis thaliana. Biochim. Biophys. Acta-Gene Regul. Mech. 2017, 1860, 218–226. [Google Scholar] [CrossRef]
- Kato, H.; Saito, T.; Ito, H.; Komeda, Y.; Kato, A. Overexpression of the TIR-X gene results in a dwarf phenotype and activation of defense-related gene expression in Arabidopsis thaliana. J. Plant Physiol. 2014, 171, 382–388. [Google Scholar] [CrossRef]
- Yan, Y.; Stolz, S.; Chételat, A.; Reymond, P.; Pagni, M.; Dubugnon, L.; Farmer, E.E. A Downstream Mediator in the Growth Repression Limb of the Jasmonate Pathway. Plant Cell 2007, 19, 2470–2483. [Google Scholar] [CrossRef]
- Breitenbach, H.H.; Wenig, M.; Wittek, F.; Jordá, L.; Maldonado-Alconada, A.M.; Sarioglu, H.; Colby, T.; Knappe, C.; Bichlmeier, M.; Pabst, E.; et al. Contrasting Roles of the Apoplastic Aspartyl Protease Apoplastic, Enhanced Disease Susceptibility1-Dependent1 and Legume Lectin-Like Protein1 in Arabidopsis Systemic Acquired Resistance. Plant Physiol. 2014, 165, 791–809. [Google Scholar] [CrossRef]
- Knoth, C.; Eulgem, T. The oomycete response gene LURP1 is required for defense against Hyaloperonospora parasitica in Arabidopsis thaliana. Plant J. 2008, 55, 53–64. [Google Scholar] [CrossRef]
- Gonzalez, L.E.; Keller, K.; Chan, K.X.; Gessel, M.M.; Thines, B.C. Transcriptome analysis uncovers Arabidopsis F-BOX STRESS INDUCED 1 as a regulator of jasmonic acid and abscisic acid stress gene expression. BMC Genomics 2017, 18, 533. [Google Scholar] [CrossRef] [PubMed]
- Zhang, J.; Gao, J.; Zhu, Z.; Song, Y.; Wang, X.; Wang, X.; Zhou, X. MKK4/MKK5-MPK1/MPK2 cascade mediates SA-activated leaf senescence via phosphorylation of NPR1 in Arabidopsis. Plant Mol. Biol. 2020, 102, 463–475. [Google Scholar] [CrossRef] [PubMed]
- Lokdarshi, A.; Conner, W.C.; McClintock, C.; Li, T.; Roberts, D.M. Arabidopsis CML38, a Calcium Sensor That Localizes to Ribonucleoprotein Complexes under Hypoxia Stress. Plant Physiol. 2016, 170, 1046–1059. [Google Scholar] [CrossRef] [PubMed]
- Lee, H.; Ganguly, A.; Baik, S.; Cho, H.-T. Calcium-dependent protein kinase 29 modulates PIN-FORMED polarity and Arabidopsis development via its own phosphorylation code. Plant Cell 2021, 33, 3513–3531. [Google Scholar] [CrossRef] [PubMed]
- Maple, R.; Zhu, P.; Hepworth, J.; Wang, J.-W.; Dean, C. Flowering time: From physiology, through genetics to mechanism. Plant Physiol. 2024, 195, 190–212. [Google Scholar] [CrossRef]
- Houben, M.; Van de Poel, B. 1-Aminocyclopropane-1-Carboxylic Acid Oxidase (ACO): The Enzyme That Makes the Plant Hormone Ethylene. Front. Plant Sci. 2019, 10, 695. [Google Scholar] [CrossRef]
- Sessa, G.; Morelli, G.; Ruberti, I. The Athb-1 and-2 HD-Zip domains homodimerize forming complexes of different DNA binding specificities. EMBO J. 1993, 12, 3507–3517. [Google Scholar] [CrossRef]
- Sessa, G.; Morelli, G.; Ruberti, I. DNA-binding specificity of the homeodomain-leucine zipper domain. J. Mol. Biol. 1997, 274, 303–309. [Google Scholar] [CrossRef] [PubMed]
- Palena, C.M.; Gonzalez, D.H.; Chan, R.L. A monomer-dimer equilibrium modulates the interaction of the sunflower homeodomain leucine-zipper protein Hahb-4 with DNA. Biochem. J. 1999, 341, 81–87. [Google Scholar] [CrossRef]
- Perotti, M.F.; Arce, A.L.; Chan, R.L. The underground life of homeodomain-leucine zipper transcription factors. J. Exp. Bot. 2021, 72, 4005–4021. [Google Scholar] [CrossRef]
- Żyła, N.; Babula-Skowrońska, D. Evolutionary Consequences of Functional and Regulatory Divergence of HD-Zip I Transcription Factors as a Source of Diversity in Protein Interaction Networks in Plants. J. Mol. Evol. 2023, 91, 581–597. [Google Scholar] [CrossRef]
- Sessa, G.; Carabelli, M.; Sassi, M. The Ins and Outs of Homeodomain-Leucine Zipper/Hormone Networks in the Regulation of Plant Development. Int. J. Mol. Sci. 2024, 25, 5657. [Google Scholar] [CrossRef]
- Manavella, P.A.; Dezar, C.A.; Bonaventure, G.; Baldwin, I.T.; Chan, R.L. HAHB4, a sunflower HD-Zip protein, integrates signals from the jasmonic acid and ethylene pathways during wounding and biotic stress responses. Plant J. 2008, 56, 376–388. [Google Scholar] [CrossRef] [PubMed]
- Zhang, Y.; Turner, J.G. Wound-Induced Endogenous Jasmonates Stunt Plant Growth by Inhibiting Mitosis. PLoS ONE 2008, 3, e3699. [Google Scholar] [CrossRef] [PubMed]
- Guo, Q.; Major, I.T.; Howe, G.A. Resolution of growth–defense conflict: Mechanistic insights from jasmonate signaling. Curr. Opin. Plant Biol. 2018, 44, 72–81. [Google Scholar] [CrossRef] [PubMed]
- Kim, H.J.; Park, J.-H.; Kim, J.; Kim, J.J.; Hong, S.; Kim, J.; Kim, J.H.; Woo, H.R.; Hyeon, C.; Lim, P.O.; et al. Time-evolving genetic networks reveal a NAC troika that negatively regulates leaf senescence in Arabidopsis. Proc. Natl. Acad. Sci. USA 2018, 115, E4930–E4939. [Google Scholar] [CrossRef]
- Cai, J.; Panda, S.; Kazachkova, Y.; Amzallag, E.; Li, Z.; Meir, S.; Rogachev, I.; Aharoni, A. A NAC triad modulates plant immunity by negatively regulating N-hydroxy pipecolic acid biosynthesis. Nat. Commun. 2024, 15, 7212. [Google Scholar] [CrossRef]
- Jiang, J.; Ma, S.; Ye, N.; Jiang, M.; Cao, J.; Zhang, J. WRKY transcription factors in plant responses to stresses. J. Integr. Plant Biol. 2017, 59, 86–101. [Google Scholar] [CrossRef]
- Jing, Y.; Lin, R. The VQ Motif-Containing Protein Family of Plant-Specific Transcriptional Regulators. Plant Physiol. 2015, 169, 371–378. [Google Scholar] [CrossRef]
- Ülker, B.; Shahid Mukhtar, M.; Somssich, I.E. The WRKY70 transcription factor of Arabidopsis influences both the plant senescence and defense signaling pathways. Planta 2007, 226, 125–137. [Google Scholar] [CrossRef]
- Besseau, S.; Li, J.; Palva, E.T. WRKY54 and WRKY70 co-operate as negative regulators of leaf senescence in Arabidopsis thaliana. J. Exp. Bot. 2012, 63, 2667–2679. [Google Scholar] [CrossRef]
Disclaimer/Publisher’s Note: The statements, opinions and data contained in all publications are solely those of the individual author(s) and contributor(s) and not of MDPI and/or the editor(s). MDPI and/or the editor(s) disclaim responsibility for any injury to people or property resulting from any ideas, methods, instructions or products referred to in the content. |
© 2025 by the authors. Licensee MDPI, Basel, Switzerland. This article is an open access article distributed under the terms and conditions of the Creative Commons Attribution (CC BY) license (https://creativecommons.org/licenses/by/4.0/).